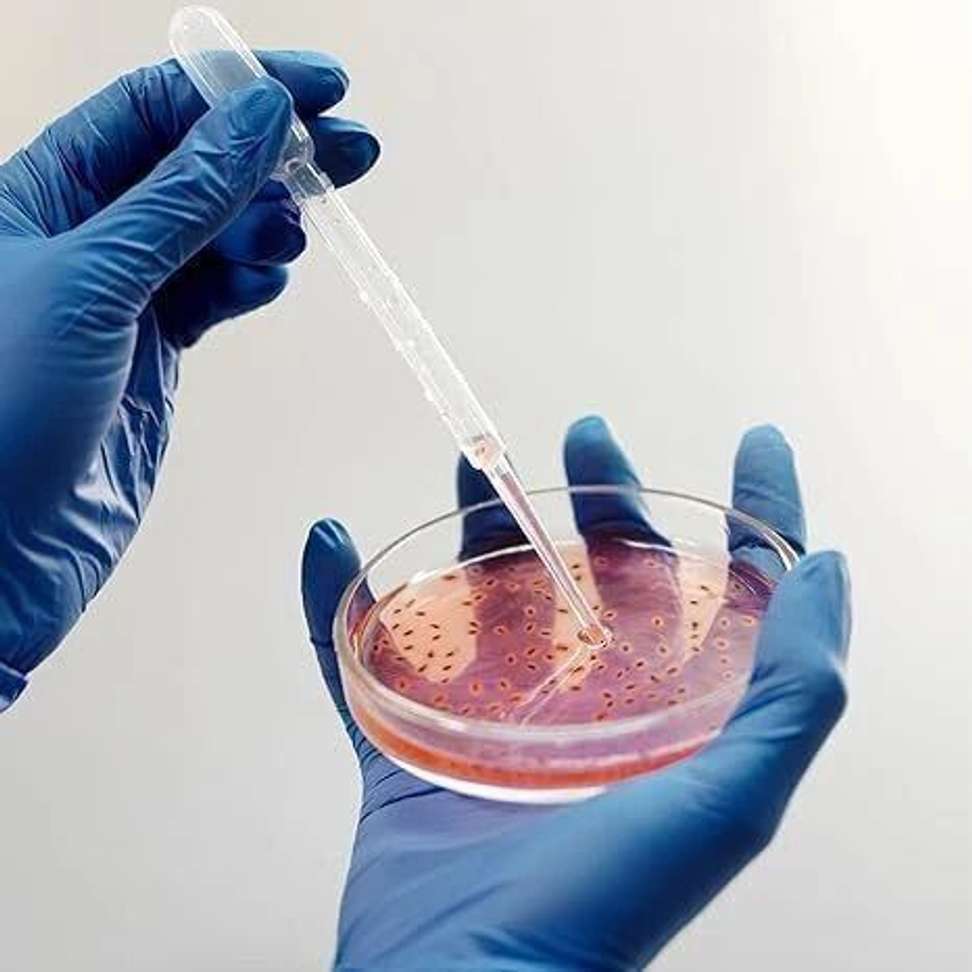
Image Placeholder

Add to cart
Buy Now
/
Spylx Glass Reusable Petri Dish (100 mm Pack of 1)
Spylx Glass Reusable Petri Dish (100 mm Pack of 1)
62% off
599
₹222
Find a seller that delivers to you
Enter pincode
•
NA
Specifications
Read More
Be the first to ask about this product
POST YOUR QUESTION
Sold By
Jianscientificindustri
4.2 ★
ABOUTContact UsCareers
Mail Us:Flipkart Internet Private Limited,Buildings Alyssa, Begonia &Clove Embassy Tech Village,Outer Ring Road, Devarabeesanahalli Village,Bengaluru, 560103,Karnataka, India
Registered Office Address:Flipkart Internet Private Limited,Buildings Alyssa, Begonia &Clove Embassy Tech Village,Outer Ring Road, Devarabeesanahalli Village,Bengaluru, 560103,Karnataka, IndiaCIN : U51109KA2012PTC066107
Telephone: 044-45614700

